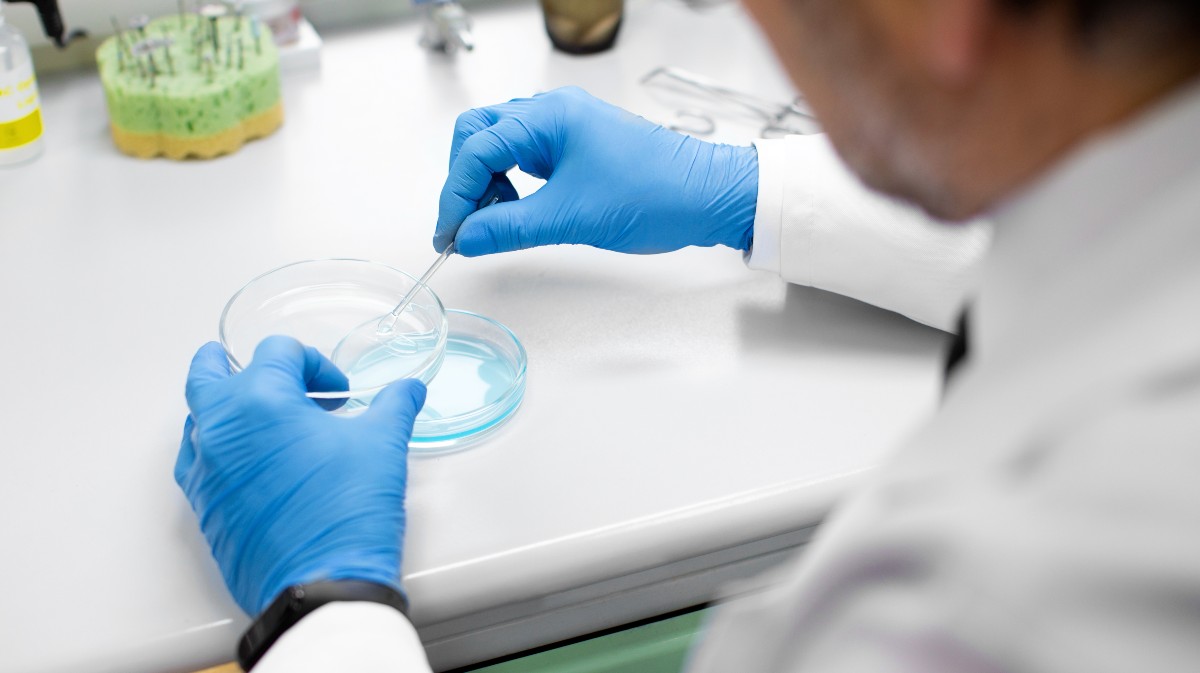

Del Lunes, 04 de Mayo de 2026 al Sábado, 09 de Mayo de 2026
El V Congreso Autonómico de Personas Afectadas por el Cáncer se celebrará los días 21 y 22 de noviembre en el Centro de Congresos y Exposiciones Lienzo Norte. 'Esperanza es mucho más: avances terapéuticos, cuidados y calidad de vida' será su título.
El anuncio ha sido realizado por la Asociación Española contra el Cáncer (AECC) de Ávila, María Dolores Rodríguez Bautista, y el presidente del Comité Técnico de la AECC de Ávila, Jesús Hernández, acompañados por la teniente de alcalde de Servicios Sociales del Ayuntamiento de Ávila, Paloma del Nogal; el presidente de la Diputación, Carlos García; el delegado territorial de la Junta, José Francisco Hernández; y el subdelegado del Gobierno, Fernando Galeano.
Rodríguez Bautista ha comentado que se espera una asistencia de entre 250 y 300 personas a este congreso autonómico que está dirigido a pacientes, sus familiares, voluntarios y la población en general, que recibirán una "información rigurosa" con el objetivo de que sean "gestores de su propio proceso oncológico".
Asimismo, la presidenta provincial de la AECC ve en esta cita una "oportunidad" para "eliminar tabúes" y para "desechar mitos erróneos" en torno a esta enfermedad.
Por su parte, Jesús Hernández ha desgranado un programa que está compuesto por cinco mesas de diálogo y tres talleres, en una apuesta por un congreso con "más diálogo y menos conferencias".
La cita arrancará con la lectura de las necesidades por parte de una paciente oncológica, que dará paso a la conferencia magistral inaugural a cargo del oncólogo del Hospital Universitario de Valladolid, Rafael López, y del hematólogo del Clínico de Salamanca, Jesús María Hernández.
Consejero de Sanidad
Ambos disertarán acerca de las 'Novedades terapéuticas en tumores sólidos y hematológicos', tras lo cual se iniciará un congreso al que está previsto que acuda el consejero de Sanidad de la Junta de Castilla y León, Alejandro Vázquez, según ha anunciado el delegado territorial.
Este último ha hecho hincapié en la necesidad de la prevención a través de los programas de cribado, después de destacar la colaboración de la Administración autonómica con la AECC con la adjudicación del hospital de día oncohematológico, con una inversión cercana a los tres millones de euros.
Por su parte, el presidente de la Diputación se ha referido a la cesión de dos viviendas para los pacientes de los pueblos que se tengan que desplazar a la capital para asistir a las sesiones de radioterapia y quimioterapia.
La teniente de alcalde de Servicios Sociales del Ayuntamiento de Ávila ha reafirmado el "compromiso" del Consistorio con la AECC, mientras que el subdelegado del Gobierno ha agradecido a la asociación su labor y la colaboración con las internas del Centro Penitenciario de Brieva. Además, ha recordado la entrada en vigor este año del derecho al olvido oncológico.
En su intervención, Rodríguez Bautista ha pedido a las administraciones "compromiso y consenso" en torno a la detección precoz y la prevención de esta enfermedad. "Necesitamos esa unidad para poder tener datos sobre el cáncer", ha sostenido, antes de pedir a las diferentes comunidades autónomas que "se adhieran" al estudio sobre la evolución de los programas de cribado para evaluarlos y mejorar".

Morenos | Jueves, 30 de Octubre de 2025 a las 21:55:55 horas
Pues que invite el moreno de Tiñosillos a su colega Moreno Bonilla, que ese sabe mucho del tema.
Accede para votar (0) (0) Accede para responder